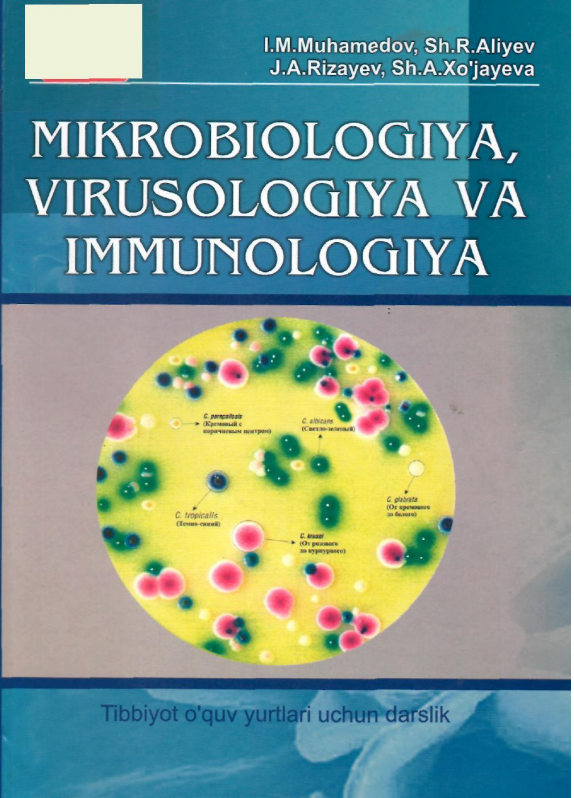
Mikrobiologiya, virusologiya va immunologiya

-
Mikrobiologiya, virusologiya va immunologiya
I.M.Muhamedov, SH.R.Aliyev, J.A.Rizayev, SH.A.Xo`jayeva,Virusologiya, -
-
-
-
-
-
Mikrobiologiya, virusologiya va immunologiya
I.M.Muhamedov, SH.R.Aliyev, J.A.Rizayev, SH.A.Xo`jayeva,Darslik tibbiyot oliy o`quv yurtlari talabalari, Bakteriologiya va virusologiya mutaxasisligi magistrlari va turli darajadagi bakteriologik labaratoriyalarda ishiayotgan shifokorlar uchun tavsiya etiladi.
-
Молекулярные основы патогенности вирусов
А.Г.Букринская,Книга «Молекулярные основы патогенности вирусов» авторства А. Г. Букринской и В. М. Жданова — это фундаментальное научное издание, опубликованное в 1991 году под эгидой Академии медицинских наук СССР и посвящённое молекулярным механизмам, определяющим способность вирусов вызывать заболевания у организмов-хозяев.
-
-
-
Virusologiya asoslari
A.H.Vahobov,Darslik oliy ta'lim muassasalarining biologiya ta'lim yo'nalishi bo'yicha tahsil olayotgan talabalari uchun mo'ljallangan bo'lib, Davlat ta'lim standartlari va Virusologiya fani dasturiga mos ravishda tayyorlangan.
-
Virusologiya asoslari
A.H.Vahobov,Darslik oliy ta'lim muassasalarining biologiya ta'lim yo`nalishlari bo`yicha tahsil olayotgan talabalar uchun mo`ljallangan bo`lib, davlat ta'lim standarti va "Virusologiya" fani dasturiga mos ravishda tayyorlangan. Darslikda virusologiya predmeti va tarixi, viruslarni fizik va kimyoviy usullarda tozalash, viruslarni morfologiyasi va strukturasi, viruslar bioximiyasi, odam va hayvon viruslari oilalari va ba'zi kasalliklari haqida bayon qilingan.